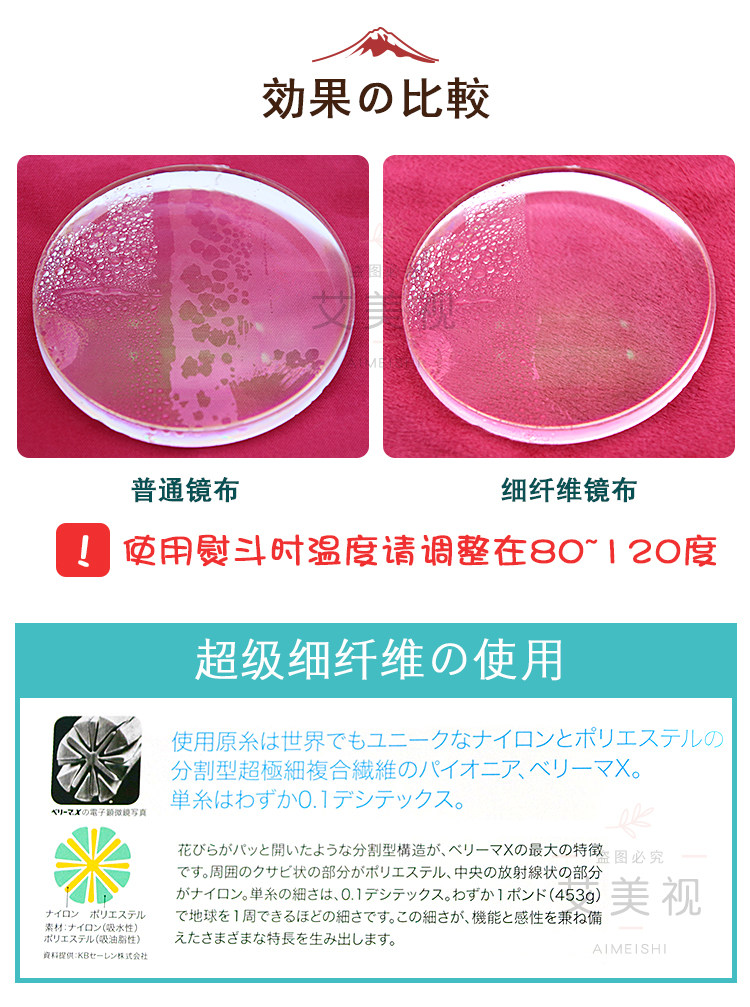

Японские импортные очки, большая высококачественная сумка

Цена: 2 008руб. (¥95)
Артикул: 561993923899
Вес товара: ~0.7 кг. Указан усредненный вес, который может отличаться от фактического. Не включен в цену, оплачивается при получении.
Описание товараPGltZyBzcmM9Imh0dHBzOi8vaW1nLmFsaWNkbi5jb20vaW1nZXh0cmEvaTMvMzI0MjU4MDU1NC9PMUNOMDFjN21WRVYxRnhtQlU2RXBZQV8hITMyNDI1ODA1NTQuanBnIj48aW1nIHNyYz0iaHR0cHM6Ly9pbWcuYWxpY2RuLmNvbS9pbWdleHRyYS9pMi8zMjQyNTgwNTU0L08xQ04wMXdKd3FQVTFGeG03Q1RQdmtlXyEhMzI0MjU4MDU1NC5qcGciPjxpbWcgc3JjPSJodHRwczovL2ltZy5hbGljZG4uY29tL2ltZ2V4dHJhL2kxLzMyNDI1ODA1NTQvTzFDTjAxQnFPanMwMUZ4bTdDekMzZ0lfISEzMjQyNTgwNTU0LmpwZyI+PGltZyBzcmM9Imh0dHBzOi8vaW1nLmFsaWNkbi5jb20vaW1nZXh0cmEvaTEvMzI0MjU4MDU1NC9PMUNOMDFPOU5sbWIxRnhtN0U1VGxMZl8hITMyNDI1ODA1NTQuanBnIj48aW1nIHNyYz0iaHR0cHM6Ly9pbWcuYWxpY2RuLmNvbS9pbWdleHRyYS9pMy8zMjQyNTgwNTU0L08xQ04wMVY0OFVoMDFGeG03OW45SXJqXyEhMzI0MjU4MDU1NC5qcGciPjxpbWcgc3JjPSJodHRwczovL2ltZy5hbGljZG4uY29tL2ltZ2V4dHJhL2k0LzMyNDI1ODA1NTQvTzFDTjAxUDRLbjBWMUZ4bTdHRGE2RDJfISEzMjQyNTgwNTU0LmpwZyI+PGltZyBzcmM9Imh0dHBzOi8vaW1nLmFsaWNkbi5jb20vaW1nZXh0cmEvaTQvMzI0MjU4MDU1NC9PMUNOMDFlZkxDb2cxRnhtN0RwSDVrb18hITMyNDI1ODA1NTQuanBnIj48aW1nIHNyYz0iaHR0cHM6Ly9pbWcuYWxpY2RuLmNvbS9pbWdleHRyYS9pMy8zMjQyNTgwNTU0L08xQ04wMWh3dXhndzFGeG03RkZERFRnXyEhMzI0MjU4MDU1NC5qcGciPjxpbWcgc3JjPSJodHRwczovL2ltZy5hbGljZG4uY29tL2ltZ2V4dHJhL2k0LzMyNDI1ODA1NTQvTzFDTjAxcFlGR2pQMUZ4bTdDVE52MjBfISEzMjQyNTgwNTU0LmpwZyI+PGltZyBzcmM9Imh0dHBzOi8vaW1nLmFsaWNkbi5jb20vaW1nZXh0cmEvaTIvMzI0MjU4MDU1NC9PMUNOMDFkTnMxUXQxRnhtN0RwRFhNbl8hITMyNDI1ODA1NTQuanBnIj48aW1nIHNyYz0iaHR0cHM6Ly9pbWcuYWxpY2RuLmNvbS9pbWdleHRyYS9pMS8zMjQyNTgwNTU0L08xQ04wMTNhZWpCRTFGeG03RTVUVWpLXyEhMzI0MjU4MDU1NC5qcGciPjxpbWcgc3JjPSJodHRwczovL2ltZy5hbGljZG4uY29tL2ltZ2V4dHJhL2kxLzMyNDI1ODA1NTQvTzFDTjAxcE85Q1I3MUZ4bTdGRjluUldfISEzMjQyNTgwNTU0LmpwZyI+PGltZyBzcmM9Imh0dHBzOi8vaW1nLmFsaWNkbi5jb20vaW1nZXh0cmEvaTIvMzI0MjU4MDU1NC9PMUNOMDFTUXVCdjYxRnhtN0U1VVpHS18hITMyNDI1ODA1NTQuanBnIj48aW1nIHNyYz0iaHR0cHM6Ly9pbWcuYWxpY2RuLmNvbS9pbWdleHRyYS9pMi8zMjQyNTgwNTU0L08xQ04wMTBzTk0xczFGeGx6OVJSSFYyXyEhMzI0MjU4MDU1NC5qcGciPjxpbWcgc3JjPSJodHRwczovL2ltZy5hbGljZG4uY29tL2ltZ2V4dHJhL2kxLzMyNDI1ODA1NTQvTzFDTjAxcUU4NDdBMUZ4bTdDVFFmV1JfISEzMjQyNTgwNTU0LmpwZyI+PGltZyBzcmM9Imh0dHBzOi8vaW1nLmFsaWNkbi5jb20vaW1nZXh0cmEvaTIvMzI0MjU4MDU1NC9PMUNOMDFSZ3FjcW4xRnhtNzhKWGZCbV8hITMyNDI1ODA1NTQuanBnIj48aW1nIHNyYz0iaHR0cHM6Ly93d3cubzBiLmNuL2kucGhwP3QucG5nJnJpZD1ndy0xLjY2Y2U3NmFlMDFmN2MmcD0xOTU5NDU0Mzg0Jms9ZS5jb20mdD0xNzI0ODA2ODMxIiBzdHlsZT0iZGlzcGxheTpub25lIj4=
Продавец:艾美视光学
Рейтинг:

Всего отзывов:0
Положительных:0
Выберите вариацию / цвет
Добавить в корзину
- Информация о товаре
- Фотографии
| Цвет: | Светло-желтый, Темно-синий, Розовый, Красный |